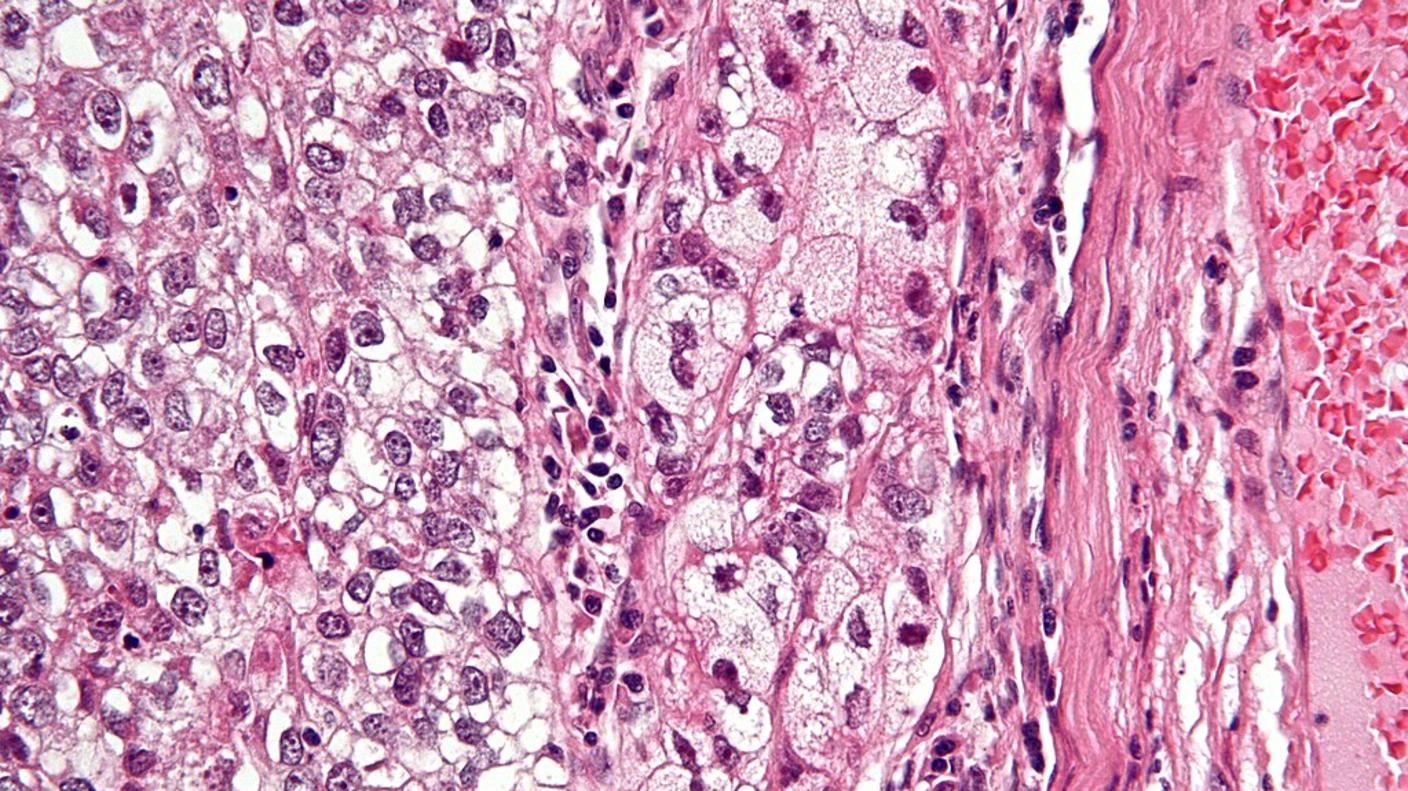
Very high magnification micrograph of a sebaceous tumor with H&E stain (pink and purple).

Clinical Genetics Branch

Working towards understanding the causes of cancer to end the burden of cancer in families and populations.
Clinical Genetics Branch (CGB) investigators study individuals and populations at high genetic risk of cancer in order to improve our understanding of cancer etiology and to advance clinical care. Our multidisciplinary approach combines clinical, genetic, genomic, epidemiologic, behavioral, statistical, and laboratory scientific research modalities. Read about some of our contributions to improving public health for these high-risk individuals.
Research Mission
The mission of CGB is to conduct clinical, genomic, and epidemiologic cancer research and translate that knowledge to improve prevention, screening, and management of cancer in families and populations at high risk. Learn about CGB's research areas.
Fellowships
CGB fellows work with researchers engaged in conducting clinical, genetic, and epidemiologic studies focused on high-risk families, individuals, and populations. They pursue astute clinical observations that might provide new clues to cancer etiology, and apply and develop epidemiologic methods to the study of high-risk individuals.
Clinical Epidemiology Unit
The Clinical Epidemiology Unit (CEU) within CGB conducts etiologic research with potential clinical and public health applications and leads studies evaluating population-based early detection and cancer prevention strategies.
Recent News from CGB
-
Genomic Landscape of Sebaceous Tumors
Genomic Landscape of Sebaceous TumorsStudy identifies key diagnostic and therapeutic targets for this rare, aggressive skin cancer.
-
 Cervical Cancer Screening: Somatic Mutations
Cervical Cancer Screening: Somatic MutationsDeep targeted sequencing identified hotspot driver mutations associated with outcomes
-
 Clinical Guidelines for Pediatric Melanoma
Clinical Guidelines for Pediatric MelanomaNew guidelines published for diagnosis and treatment of pediatric melanocytic tumors.
Select Publications
View a list of CGB publications.
- Starrett GJ et al. Multiomics profiling distinguishes sebaceous carcinoma from benign sebaceous neoplasms and provides insight into the genetic evolution of sebaceous carcinogenesis. Clin Canc Res. 2024.
- Hansen H et al. Management of individuals with germline pathogenic/likely pathogenic variants in CHEK2: A clinical practice resource of the American College of Medical Genetics and Genomics (ACMG). Genet Med. 2023.
- Cohen CM et al. Racial and Ethnic Disparities in Cervical Cancer Incidence, Survival, and Mortality by Histologic Subtype. J Clin Oncol. 2022.
- Brown D et al. Germline-somatic JAK2 interactions are associated with clonal expansion in myelofibrosis. Nature Commun. 2022.
- Egemen D et al. Variation in Human Papillomavirus Vaccination Effectiveness in the US by Age at Vaccination. JAMA Netw Open. 2022.
- McReynolds LJ et al. Genetic testing in severe aplastic anemia is required for optimal hematopoietic cell transplant outcomes. Blood. 2022.
- Clarke M et al. Racial and Ethnic Differences in Hysterectomy-Corrected Uterine Corpus Cancer Mortality by Stage and Histologic Subtype. JAMA Oncol. 2022.
- Sargen M, et al. Spectrum of Nonkeratinocyte Skin Cancer Risk Among Solid Organ Transplant Recipients in the US. JAMA Dermatol. 2022.
- Kuhs KAL et al. Genetic variation within the human papillomavirus type 16 genome is associated with oropharyngeal cancer prognosis. Ann Oncol. 2022.
- Gadalla SM et al. Association of donor IFNL4 genotype and non-relapse mortality after unrelated donor myeloablative haematopoietic stem-cell transplantation for acute leukaemia: a retrospective cohort study. Lancet Haematol. 2020.
- Mirabello L et al. Frequency of Pathogenic Germline Variants in Cancer-Susceptibility Genes in Patients With Osteosarcoma. JAMA Oncol. 2020.
- Wentzensen N et al. Accuracy and Efficiency of Deep-Learning-Based Automation of Dual Stain Cytology in Cervical Cancer Screening. J Natl Cancer Inst. 2020.